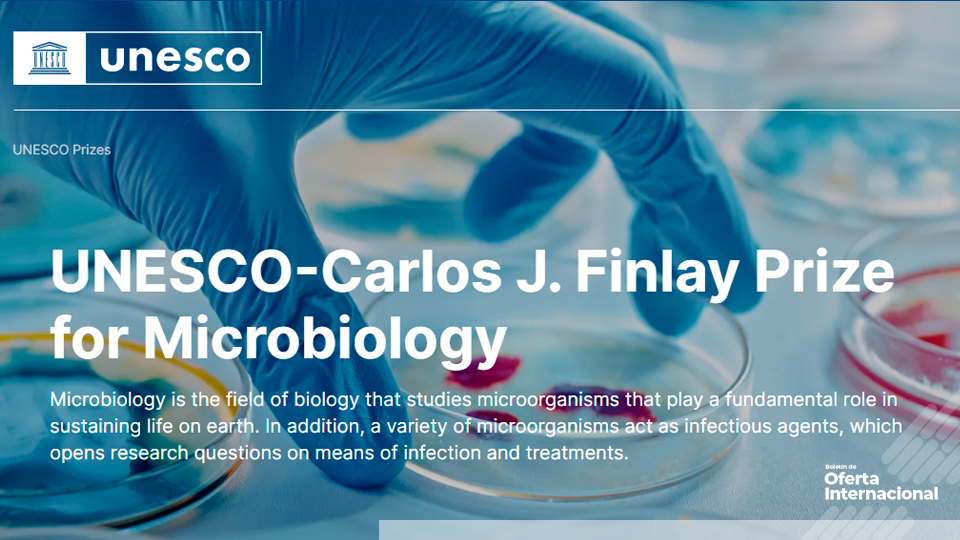
Premio internacional UNESCO que destaca contribuciones científicas en microbiología.

¡Aquí sí pasa! En ‘Bogotá, mi Ciudad, mi Casa’ tenemos planes para toda la familia en la Cinemateca de Bogotá. Te presentamos la programación completa de las películas que se presentarán el domingo 2 de noviembre de 2025. Prográmate y disfruta de lo mejor del cine. ¡Entrada con boletería!
Este contenido te puede interesar: El Museo de Bogotá abre sus puertas con la exposición 'Rodar Juntas'
La programación de cine es para toda la familia. La mejor parte es que la boleta de entrada tiene un precio increíblemente accesible y está tan solo a $7.000. Cinemateca de Bogotá El Tunal /Cinemateca de Bogotá Fontanar del Río son entrada libre.
Domingo 2 de noviembre de 2025
200% Lobo
Secuela de aventura animada de 100% lobo. Freddy Lupin, un valiente poodle con el corazón de un feroz lobo, tiene un solo objetivo: demostrar que el coraje no depende del pelaje. Pero cuando un deseo mal formulado lo transforma en un hombre lobo y pone en peligro el mundo mágico de las hadas, Freddy deberá unir fuerzas con aliados inesperados, enfrentarse a villanos peludos y redescubrir lo que realmente significa ser parte de una manada.
Día: domingo 2 de noviembre de 2025
Hora: 11:00 a. m.
Lugar: Cinemateca de Bogotá sede Centro, ubicada en la carrera Tercera No. 19 - 10.
Entrada con boletería

CREAndo documental en los barrios programa niños y niñas
Mi barrio, mi gente (Dir. The thearthes films fbl, 2025) Colombia. 8 min. Noticiero CREA (Dir. Noticiero Crea, 2025) Colombia. 10 min. Para una ciudad con heridas, un arte que sana (Dir. Colegio Fanny Mikey I.E.D., 2025) Colombia. 5 min. El dibujante (Dir. Cámara y acción, 2025) Colombia. 11 min. Aventuras Interculturales (Dir. Francisco Javier Matiz IED, 2025) Colombia. 15 min. Mi lugar favorito (Dir. Colegio Cundinamarca, 2025) Colombia. 10 min. Entre luces y sombras (Dir. San Cayetano IED, 2025) Colombia. 20 min.
Día: domingo 2 de noviembre de 2025
Hora: 11:00 a. m.
Lugar: Cinemateca de Bogotá sede Centro, ubicada en la carrera Tercera No. 19 - 10.
Entrada libre
R3 Pr0gr4m4dXs En Búsqueda del Nagual
Documental que cuestiona las enseñanzas tradicionales para llegar a Dios proponiendo un viaje interior al corazón. Esta película tipo Road Movie de dos colombianos que viajan a Colca Perú relata por medio de entrevistas un proceso de reprogramación.
Día: domingo 2 de noviembre de 2025
Hora: 1:00 p. m.
Lugar: Cinemateca de Bogotá sede Centro, ubicada en la carrera Tercera No. 19 - 10.
Entrada con boletería
Andariega
Cada año, Chena recorre el campo recogiendo la cosecha de café. Tiene 26 años y es madre soltera. A pesar de trabajar en un mundo donde prevalece la fuerza física, encuentra libertad y sosiego al poder elegir el tiempo y lugar de trabajo. Sin embargo, el costo de andar es alto, ella se está perdiendo la crianza de Deiner, su hijo de seis años y su cuerpo se está enfermando por la pesada carga laboral. Por ello, ha decidido buscar otros trabajos que ponen en entredicho su idea de libertad.
Día: domingo 2 de noviembre de 2025
Hora: 2:00 p. m.
Lugar: Cinemateca de Bogotá sede Centro, ubicada en la carrera Tercera No. 19 - 10.
Entrada con boletería
Fogo do Vento
La vid ha dado fruto, y es tiempo de cosecha. Soraia, una joven, se corta. La sangre se mezcla con el vino. Un toro negro anda suelto. Arriba, entre los robles, el tiempo se alarga, y una comunidad se refugia. Comparten pan y vino, recuerdos y sueños, la historia de un paisaje y de una lucha. Entramos en una larga noche, donde la naturaleza también habla. El viento ardiente que trae la ola de calor, quema.
Día: domingo 2 de noviembre de 2025
Hora: 2:30 p. m.
Lugar: Cinemateca de Bogotá sede Centro, ubicada en la carrera Tercera No. 19 - 10.
Entrada con boletería
La casa Emak Bakia
Una película vanguardista de Man Ray llamada Emak Bakia, en vasco “Déjame en paz”, desata la historia de una búsqueda. La casa donde se rodó en 1926 cerca de Biarritz tuvo ese peculiar nombre y Oskar Alegria decide emprender un camino a pie hacia su localización. De aquella mansión, Man Ray solo dio a conocer tres planos: la imagen de su puerta principal, dos columnas de una ventana y un trozo de costa cercana. La búsqueda a través de esas imágenes antiguas no será fácil. El nombre no figura en los archivos y nadie recuerda hoy la casa. Por eso se pedirá ayuda y colaboración a otros informantes como el azar y el viento.
Día: domingo 2 de noviembre de 2025
Hora: 3:30 p. m.
Lugar: Cinemateca de Bogotá sede Centro, ubicada en la carrera Tercera No. 19 - 10.
Entrada con boletería
Tres hermanas
La directora Joyce Ventura se filma a sí misma y a sus dos hermanas a lo largo de muchos años, reflexionando sobre el proceso de envejecer, la aceptación de la propia muerte y la de los seres queridos, y revelando las ansiedades que surgen al enfrentar el final de la vida.
Las tres hermanas, muy distintas entre sí y viviendo en ciudades diferentes, contrastan sus perspectivas existenciales y personalidades opuestas. La vejez, una etapa de la vida que a menudo elegimos ignorar pero que inevitablemente nos concierne a todos, es narrada en primera persona con humor y sensibilidad.
Día: domingo 2 de noviembre de 2025
Hora: 4:30 p. m.
Lugar: Cinemateca de Bogotá sede Centro, ubicada en la carrera Tercera No. 19 - 10.
Entrada con boletería
Sempre
Cincuenta años después, Luciana Fina revisita las imágenes de la Revolución de los Claveles de 1974 en Portugal, reconsiderando la transición del fascismo a la liberación y el proceso de construcción de un nuevo país, para su emancipación y su futuro. Es un homenaje al cine que interfirió en la historia y restituye hoy la hipótesis de un momento extraordinario. La película recorre la opresión de la dictadura y su policía política, las ocupaciones estudiantiles de 1969, el Movimiento de las Fuerzas Armadas de 1974, los sueños, programas y perspectivas del proceso revolucionario y la descolonización.
Día: domingo 2 de noviembre de 2025
Hora: 5:00 p. m.
Lugar: Cinemateca de Bogotá sede Centro, ubicada en la carrera Tercera No. 19 - 10.
Entrada con boletería
La caja negra
"En la mañana del 28 de octubre de 1969, un individuo identificado como ""David Chavarriaga"" en las costas del Pacífico colombiano desvía el vuelo HK 1022 de Avianca y lo redirige a Cuba, donde años más tarde se convertirá en un ""escritor cubano"" de culto.
Medio siglo después, cuando su presencia empieza a difuminarse, la directora de este documental se sumerge en una lucha por preservar su recuerdo y enfrentar la naturaleza fugaz de la memoria humana. Recordando la convulsa Latinoamérica de los 70, este relato reflexiona sobre el paso del tiempo, las trampas del recuerdo y la necesidad de indagar en nuestra frágil memoria colectiva."
Día: domingo 2 de noviembre de 2025
Hora: 7:00 p. m.
Lugar: Cinemateca de Bogotá sede Centro, ubicada en la carrera Tercera No. 19 - 10.
Entrada con boletería

Homenaje ALADOS: Oscar Campo- Programa: El color del tacto Sesión 2
Un ángel subterráneo (Dir. Oscar Campo, 1992) Colombia. 25 min. Informe sobre un mundo ciego (Dir. Oscar Campo, 2001) Colombia. 24 min. Ofrenda (Azucena Losana, 2023) México. 4 min. Accession (Dir. Tamer Hassan, Armand Yervant Tufenkian, 2018) Estados Unidos. 48 min. Tigre del Carbón (Azucena Losana, 2022) México, Argentina. 5 min.
Día: domingo 2 de noviembre de 2025
Hora: 8:00 p. m.
Lugar: Cinemateca de Bogotá sede Centro, ubicada en la carrera Tercera No. 19 - 10.
Entrada con boletería
Descubre más eventos, obras de teatro, conciertos, talleres, actividades, visitas guiadas, caminatas y muchos más planes para todas las edades y en familia con la Agenda Cultural de Bogotá. Haz clic en el banner.
Este contenido fue creado a partir de la información proporcionada y difundida por el Instituto Distrital de las Artes - IDARTES https://cinematecadebogota.gov.co/ . El artículo fue curado por un o una periodista del Portal Bogotá. Si tienes alguna sugerencia, observación o necesitas más información sobre la nota publicada, puedes hacerlo a través de los canales de atención a la ciudadanía de la entidad mencionada o en Bogotá te Escucha: https://bogota.gov.co/sdqs/.